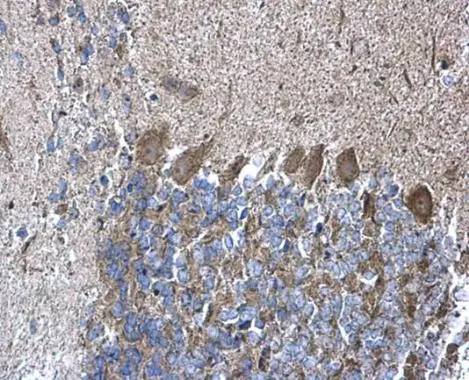
RPL5 antibody detects RPL5 protein at cytoplasm on mouse hind brain by immunohistochemical analysis. Sample: Paraffin-embedded mouse hind brain. RPL5 antibody (GTX101821) diluted at 1:500. 
 Antigen Retrieval: Trilogy? (EDTA based, pH 8.0) buffer, 15min

RPL5 antibody detects RPL5 protein by western blot analysis. A. 30 μg Rat2 whole cell lysate/extract 10% SDS-PAGE RPL5 antibody (GTX101821) dilution: 1:1000 The HRP-conjugated anti-rabbit IgG antibody (GTX213110-01) was used to detect the primary antibody.
RPL5 antibody
GTX101821
ApplicationsImmunoFluorescence, Western Blot, ImmunoCytoChemistry, ImmunoHistoChemistry, ImmunoHistoChemistry Paraffin
Product group Antibodies
ReactivityHuman, Mouse, Rat
TargetRPL5
Overview
- SupplierGeneTex
- Product NameRPL5 antibody
- Delivery Days Customer9
- Application Supplier NoteWB: 1:500-1:3000. ICC/IF: 1:100-1:1000. IHC-P: 1:100-1:1000. *Optimal dilutions/concentrations should be determined by the researcher.Not tested in other applications.
- ApplicationsImmunoFluorescence, Western Blot, ImmunoCytoChemistry, ImmunoHistoChemistry, ImmunoHistoChemistry Paraffin
- CertificationResearch Use Only
- ClonalityPolyclonal
- Concentration0.4 mg/ml
- ConjugateUnconjugated
- Gene ID6125
- Target nameRPL5
- Target descriptionribosomal protein L5
- Target synonymsL5, MSTP030, PPP1R135, uL18, large ribosomal subunit protein uL18, 60S ribosomal protein L5, protein phosphatase 1, regulatory subunit 135
- HostRabbit
- IsotypeIgG
- Protein IDP46777
- Protein NameLarge ribosomal subunit protein uL18
- Scientific DescriptionRibosomes, the organelles that catalyze protein synthesis, consist of a small 40S subunit and a large 60S subunit. Together these subunits are composed of 4 RNA species and approximately 80 structurally distinct proteins. This gene encodes a ribosomal protein that is a component of the 60S subunit. The protein belongs to the L18P family of ribosomal proteins. It is located in the cytoplasm. The protein binds 5S rRNA to form a stable complex called the 5S ribonucleoprotein particle (RNP), which is necessary for the transport of nonribosome-associated cytoplasmic 5S rRNA to the nucleolus for assembly into ribosomes. The protein interacts specifically with the beta subunit of casein kinase II. Variable expression of this gene in colorectal cancers compared to adjacent normal tissues has been observed, although no correlation between the level of expression and the severity of the disease has been found. This gene is co-transcribed with the small nucleolar RNA gene U21, which is located in its fifth intron. As is typical for genes encoding ribosomal proteins, there are multiple processed pseudogenes of this gene dispersed through the genome. [provided by RefSeq]
- ReactivityHuman, Mouse, Rat
- Storage Instruction-20°C or -80°C,2°C to 8°C
- UNSPSC41116161